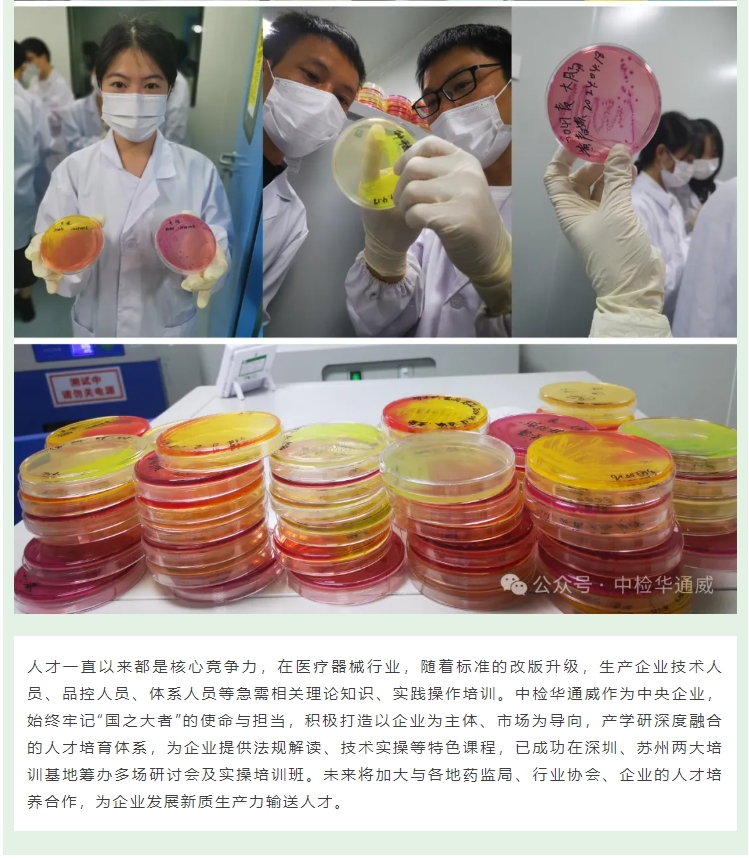

- 合规解码 助听器GBT 9706.266-2025新标发布,三招破解高效上市难题 [2026-01]
- 攻克脑胶质瘤治疗难关!中检核联产学研合作引领核药研发新突破 [2026-01]
- 即将实施丨输液、输血、注射器具生物学评价新标倒计时 [2026-01]
- 合规解码丨新版软性纤维内窥镜注册审查指导原则解读 [2026-01]
- 诚邀丨昆山医疗器械注册合规与上市策略培训 [2026-01]
- 合规解码丨等离子手术设备审评要点解析 [2026-01]
- 产品方案 腔镜吻合器国内注册NMPA [2025-12]
- 产品方案丨短波治疗仪国内注册要点 [2025-12]
- 标准解读|一次性使用卫生用品GB 15979新旧标准差异及应对 [2025-12]
- 产品方案丨微波消融设备国内注册要点 [2025-12]
- 央地合作丨中检华通威与江西省赣州市章贡区政府联合成立医疗器械技术服务中心 [2025-12]
- IVD设备标准全面实施在即,中检华通威率先通过全项能力认证 [2025-12]
- 重要合作丨苏州2025版《中国药典(四部)》医疗器械无菌检验员培训成功举办 [2025-12]
- 重要合作丨鄂尔多斯市医疗器械行业协会第一届第二次会员大会圆满召开 [2025-12]
- 重要合作丨重庆市医疗器械行业协会2025年度理事会扩大会议暨产业协作交流会圆满召开 [2025-12]
- 央地合作丨中检华通威赴贵阳市开展系列交流活动 [2025-12]
- 可重复使用医疗器械再处理——重复使用寿命有效性验证 [2025-12]
- 产品方案丨眼底相机国内注册要点 [2025-12]
- 重要合作武汉医疗器械监管论坛成功举办 [2025-12]
- 诚邀丨武汉医疗器械监管论坛 [2025-12]
- 央地合作丨中检华通威与通化医药高新区签署产业合作协议 [2025-12]
- 产品方案丨牙种植体国内注册要点 [2025-11]
- 重要合作丨聚焦临床前研究,助力企业合规发展 [2025-12]
- 产品方案丨眼科超声产品国内注册要点 [2025-12]
- 产品方案丨口腔正畸矫治器械国内注册要点 [2025-12]
- 中检核联正式揭牌启航,共筑核药产业新篇章 [2025-11]
- 央地合作 | 中国中检广东公司与苏州城投集团战略签约 [2025-11]
- 中国中检华南区域总部一行到中检华通威苏州公司调研指导 [2025-11]
- 重要合作丨 第九届云成天誉会·医疗器械审评认证技术大会成功举办 [2025-11]
- 标准换版丨国家发布新版IVD设备专用标准YYT 0648-2025 [2025-11]